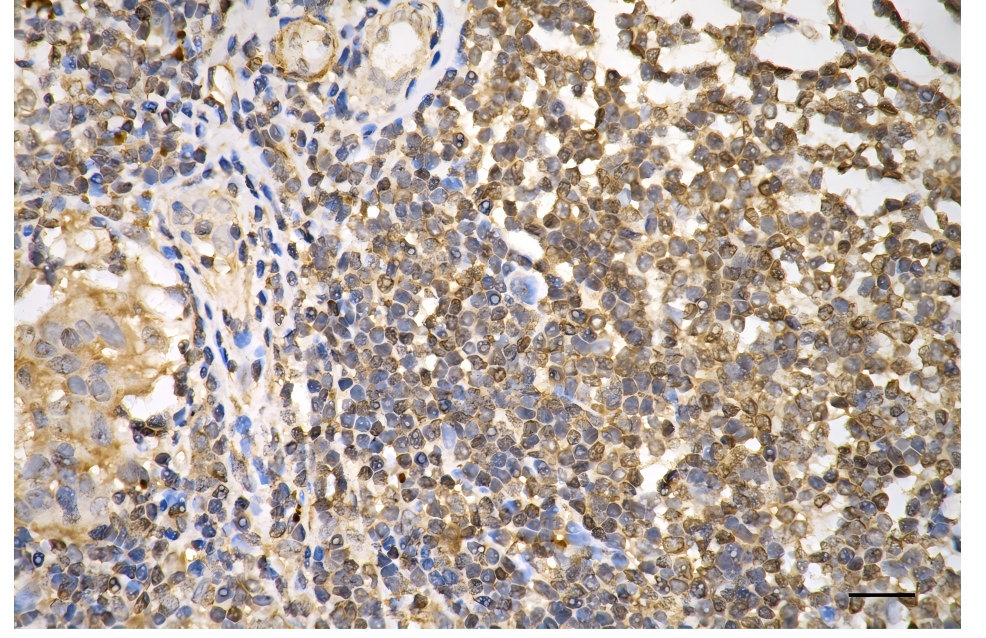

KRT18 Recombinant Monoclonal Antibody
-
中文名稱:KRT18 Recombinant Monoclonal Antibody
-
貨號:CSB-RA778851A0HU
-
規格:¥1320
-
圖片:
-
Flow cytometric analysis of Keratin 18 expression in HepG2 cells using Keratin 18 antibody. Green, isotype control; red, Keratin 18.
-
Immunocytochemical staining of HepG2 cells with Keratin 18 antibody. Nuclei were stained blue with DAPI; Keratin 18 was stained magenta with Alexa Fluor? 647. Images were taken using Leica stellaris 5. Protein abundance based on laser Intensity and smart gain: High. Scale bar: 20 μm.
-
Immunohistochemistry was performed on paraffin-embedded mouse liver using keratin 18 antibody. Antigen retrieval was done in sodium citrate buffer (pH 6.0). DAB was used for detection, with hematoxylin counterstaining. Images were acquired using a Nikon Ci-L Plus microscope (40× objective). Scale bar: 25 μm.
-
Immunohistochemistry was performed on paraffin-embedded mouse kidney using keratin 18 antibody. Antigen retrieval was done in sodium citrate buffer (pH 6.0). DAB was used for detection, with hematoxylin counterstaining. Images were acquired using a Nikon Ci-L Plus microscope (40× objective). Scale bar: 25 μm.
-
Immunohistochemistry was performed on paraffin-embedded human breast carcinoma using keratin 18 antibody. Antigen retrieval was done in sodium citrate buffer (pH 6.0). DAB was used for detection, with hematoxylin counterstaining. Images were acquired using a Nikon Ci-L Plus microscope (40× objective). Scale bar: 25 μm.
-
Western blotting analysis using Keratin 18 antibody. Total cell lysates (30 μg) from various cell lines were loaded and separated by SDS-PAGE. The blot was incubated with Keratin 18 antibody and HRP-conjugated goat anti-rabbit secondary antibody respectively.
-
-
其他:
產品詳情
-
Uniprot No.:
-
基因名:
-
別名:KRT18; Keratin 18; Cell Proliferation-Inducing Gene 46 Protein; Keratin, Type I Cytoskeletal 18; Keratin 18, Type I; CK-18; CYK18; K18; Cytokeratin 18; Cytokeratin-18; Keratin-18
-
反應種屬:Human
-
免疫原:Recombinant Human KRT18 protein
-
免疫原種屬:Homo sapiens (Human)
-
標記方式:Non-conjugated
-
克隆類型:Monoclonal
-
抗體亞型:Rabbit IgG
-
純化方式:Affinity-chromatography
-
克隆號:24B10
-
濃度:It differs from different batches. Please contact us to confirm it.
-
保存緩沖液:Rabbit IgG in PBS (pH 7.4) containing 50% glycerol, and 0.02% sodium azide.
-
產品提供形式:Liquid
-
應用范圍:ELISA, WB, FC, ICC, IHC
-
推薦稀釋比:
Application Recommended Dilution WB 1:1000-1:5000 FC 1:200-1:2000 ICC 1:100-1:1000 IHC 1:100-1:200 -
Protocols:
-
儲存條件:Upon receipt, store at -20°C or -80°C. Avoid repeated freeze.
-
貨期:Basically, we can dispatch the products out in 1-3 working days after receiving your orders. Delivery time maybe differs from different purchasing way or location, please kindly consult your local distributors for specific delivery time.
-
用途:For Research Use Only. Not for use in diagnostic or therapeutic procedures.
相關產品
靶點詳情
-
功能:Involved in the uptake of thrombin-antithrombin complexes by hepatic cells. When phosphorylated, plays a role in filament reorganization. Involved in the delivery of mutated CFTR to the plasma membrane. Together with KRT8, is involved in interleukin-6 (IL-6)-mediated barrier protection.
-
基因功能參考文獻:
- the present study demonstrated that CK18 might be served as a novel biomarker to predict clinicopathological features and the outcome of breast cancer. PMID: 29437899
- This study analyzed phase III data comparing basal insulin peglispro (BIL) and insulin glargine in type 1 (T1D), and type 2 diabetes (T2D) (insulin-naive and insulin-treated). Alanine aminotransferase (ALT), K-18, enhanced liver fibrosis scores and liver fat content. PMID: 29167192
- Results found that CK18, MMP-9, and TIMP1 averages of those with positive clinical lymph nodes and those in clinical stage 3 were higher than the averages of those with negative clinical lymph nodes and those in clinical stage 2. PMID: 29651326
- non-surviving severe malignant middle cerebral artery infarction patients had higher serum CCCK-18 levels than surviving patients PMID: 29573748
- Plasma M30-M65 levels are higher in serum of patients with placental abruption. PMID: 27893299
- results show that the caspase digestion-resistant K18 helps to maintain keratin filament organization and delays apoptosis, thereby resulting in protection from liver injury. PMID: 28606991
- The plasma keratin-18 (K18) values of nonsurviving alcoholic hepatitis (AH) patients were significantly elevated above their surviving counterparts and healthy controls PMID: 28770701
- Evidence suggested that the modification of histone H3 was highly correlated with the modulation of cytokeratin 18 and probably plays an important role in tumorigenesis of hepatocytes PMID: 28647696
- K8/K18 interact with Notch1 and regulate Notch1 signalling activity during differentiation of the colonic epithelium. PMID: 28475172
- FIB-4 index and CK-18F have good diagnostic abilities not only for nonalcoholic steatohepatitis (NASH) overall, but also for NASH with mild fibrosis. PMID: 29040984
- In children with nonalcoholic fatty liver disease, CK18 levels were found to be significantly higher in subjects with any fibrosis compared with those without fibrosis (304.6 +/- 124.8 vs 210.4 +/- 70.9, P < 0.001). PMID: 26835904
- CK18 combined with uric acid measurement is a promising non-invasive biomarker for prediction of disease severity in NASH patients PMID: 28472039
- Results suggested that serum M65 is a useful indicator of liver inflammation in chronic hepatitis B patients. Serum M65, not M30, is valuable in the grading of liver fibrosis. PMID: 28514295
- The results suggest that increased circulating CK-18 and FGF-21 are associated with Nonalcoholic Fatty Liver Disease and may be used for initial assessment, but not enough PMID: 28326329
- The purpose of this study is to investigate the immunohistochemical expression of cytokeratin 18 (CK18) and the reactivity to GDF5 (CDMP-1), called the morphogenetic protein-1, cartilage-derived, in lingual squamous cell carcinoma. PMID: 27151703
- In patients with anterior STEMI treated with primary PCI, the apoptosis marker M30 might be useful for predicting LV remodeling and subsequent LV systolic dysfunction. PMID: 27479531
- Serum concentrations of CK-18 fragments and transgelin-2 correlate with the severity of NAFLD, but not with obesity. PMID: 27740519
- High KRT18 serum levels are associated with non-small-cell lung cancer. PMID: 27468866
- Serum HGF and CK18 levels were significantly up-regulated and positively correlated with metastasis stage, tumor stage, and disease stage of esophageal squamous cell carcinoma. PMID: 27706656
- CK18 plays an important role in lung cancer progression and may be a therapeutic target for non small cell lung cancer. PMID: 27601168
- these results suggest that cytokeratin 18 critically contributes to initiating TGF-beta1-induced EMT via the smad 2/3-mediated regulation of snail and slug expression in breast epithelial cells. PMID: 27734227
- Study demonstrated that the downregulation of CK18 is associated with the acquisition of paclitaxel-resistance and tumor aggressiveness in prostate cancer. PMID: 26892177
- Data indicate that O-GlcNAcylation at serine Ser30 determines the occurrence of Pposphorylation at Ser33 on Keratin 18 (K18). PMID: 27059955
- Data show that adipose-derived stem cells (ADSC) differentiate into epithelial-like cells with the expression of epithelial surface marks cytokeratin 18 and 19 and form tube-like structures. PMID: 26416346
- High circulating CCCK-18 levels were associated with injury severity and a poor clinical outcome after aSAH and CCCK-18 had the potential to be a good prognostic biomarker for aSAH. PMID: 26671131
- NAFLD patients, serum CK-18 levels reflect disease activity scores and correlate with histological changes. PMID: 26436355
- Data show that the decrease of keratin 18 (K18) ser33 and ser52 phosphorylation inhibited autophagy and decreased apoptosis of HCT116 cells. PMID: 26728375
- As an apoptosis-related biomarker, serum M30 [M30 cytokeratin-18 peptide, human ] level has a merit to be the most promising test for prediction or differential diagnosis of HELLP syndrome in PE patients. PMID: 26138305
- Serum caspase-cleaved cytokeratin-18 levels are associated with 30-day mortality and could be used as a prognostic biomarker in patients with severe traumatic brain injury. PMID: 25822281
- The results suggest that oblongifolin C inhibits metastasis through the induction of the expression of keratin 18 and may be useful in cancer therapy. PMID: 25973684
- Our results suggest that reliable detection of apoptosis via the M30 assay only works when sufficient levels of cytokeratin 18 are present in the cells. This means that the M30 assay may result in false negative results for apoptosis PMID: 25846732
- No evidence of association between polymorphisms in KRT18 and sporadic amyotrophic lateral sclerosis in Han Chinese PMID: 25677198
- Variants in highly conserved residues of K18 Asp89His (isoniazid-related) were found in patients with fatal Drug-induced liver injury. PMID: 26286715
- Serum caspase-cleaved cytokeratin-18 levels were associated with mortality in severe septic patients. PMID: 25290885
- Although only serum M65 levels were found to be of diagnostic value, neither M30 nor M65 serum levels played a prognostic role in the outcome in melanoma patients. PMID: 23812330
- Under the present study design propofol or sevoflurane anaesthesia did not induce apoptosis or affected the liver function as assessed by the M30, M65 markers and liver enzymes in patients undergoing mastectomy or thyroidectomy under general anaesthesia. PMID: 25579144
- There were no statistically significant correlations between serum M30 and M65 concentrations and clinicodemographical variables. Serum M30 and M65 concentrations were found to have a diagnostic value in nasopharyngeal cancer PMID: 25326440
- The broken dialog between ANXA1 and CK18 in normal breast tissues may play a critical role in breast cancer development. PMID: 25028131
- The distribution of CK18 in a large cohort of older people with type 2 diabetes is associated with an adverse metabolic risk factor profile. PMID: 24237940
- placental expression significantly increased in preeclampsia compared to normotensive pregnancies PMID: 24857367
- Full length and caspase cleaved cytokeratin 18 (detected as M65 and M30 antigens) are associated with prognosis in hepatitis B virus-related acute-on-chronic liver failure. PMID: 24605039
- KRT18 expression is directly regulated by EGR1, and contributes to decrease malignancy of non-small cell lung carcinoma. PMID: 24990820
- we identified four proteins with different expression in paclitaxel resistant cells, i.e., serpin B3, serpin B4, heat shock protein 27 (all three upregulated) and cytokeratin 18 (downregulated). PMID: 24898082
- effect between the CK-18 concentration and the severity of NAFLD was found in the T2DM patients PMID: 24667697
- Due to promising results of various studies, CK-18 cell death markers could be applied in clinical routine soon. PMID: 24622872
- Median serum concentration of M30-CK18 was higher in chronic hepatitis C patients and was associated with inflammatory activity and liver fibrosis. PMID: 23981197
- A new model that combines ALT, platelets, CK-18 fragments, and triglycerides was established by logistic regression among nonalcoholic fatty liver disease patients. PMID: 24324749
- Serum M65 has the potential as a new diagnostic parameter for hepatocellular carcinoma (HCC) and serum CD163 is a new prognostic parameter in HCC patients. PMID: 23792028
- M 30 serum levels increase in patients with active ulcerative colitis. PMID: 23945185
- These results provide an explanation for the elevated serum levels of HSP-27, HSP-70, and ccCK-18 found in COPD patients, indicating that hypoxic conditions can trigger the release of the aforementioned factors. PMID: 24660549
顯示更多
收起更多
-
相關疾病:Cirrhosis (CIRRH)
-
亞細胞定位:Cytoplasm, perinuclear region. Nucleus, nucleolus.
-
蛋白家族:Intermediate filament family
-
組織特異性:Expressed in colon, placenta, liver and very weakly in exocervix. Increased expression observed in lymph nodes of breast carcinoma.
-
數據庫鏈接:
Most popular with customers
-
-
YWHAB Recombinant Monoclonal Antibody
Applications: ELISA, WB, IHC, IF, FC
Species Reactivity: Human, Mouse, Rat
-
Phospho-YAP1 (S127) Recombinant Monoclonal Antibody
Applications: ELISA, WB, IHC
Species Reactivity: Human
-
-
-
-
-